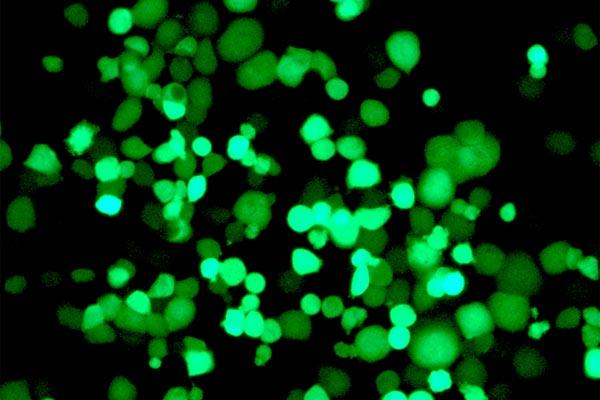

Investigadores del IDIBAPS y el IRB Barcelona demuestran la eficacia de una nueva estrategia para conseguir que los virus infecten sólo a las células del tumor y preserven las de los tejidos sanos.
Científicos del Instituto de Investigaciones Biomédicas August Pi i Sunyer (IDIBAPS) y del Instituto de Investigación Biomédica (IRB Barcelona) lideran un estudio en el que han diseñado una nueva estrategia para conseguir que virus modificados genéticamente ataquen de forma selectiva a las células tumorales sin que las sanas se vean afectadas. El artículo, que publica la revista Nature Communications, es fruto del trabajo de tesis doctoral de Eneko Villanueva y lo han co-liderado Cristina Fillat, jefe del grupo terapia Génica y Cáncer del IDIBAPS, y Raúl Méndez, investigador ICREA del IRB Barcelona.
El tratamiento convencional del cáncer puede provocar efectos secundarios no deseados como consecuencia de una poca selectividad. Para evitarlos es importante que los nuevos tratamientos sean capaces de eliminar de forma eficiente las células cancerígenas y preservar las células sanas. Una de las nuevas terapias en cáncer se basa en el desarrollo de virus oncolíticos, es decir, virus modificados para que sólo infecten a las células tumorales. En los últimos años se han creado virus mediante ingeniería genética para maximizar su efecto anticancerígeno, pero a medida que la potencia del virus aumenta, también lo hace la toxicidad asociada. Limitar este efecto sobre las células sanas es ahora la clave para la aplicación de este tipo de terapias.
Un abordaje innovador y específico
En el artículo publicado en la revista Nature Communications, los investigadores del IDIBAPS y el IRB Barcelona han desarrollado un abordaje innovador para dotar a un adenovirus de una alta especificidad contra las células tumorales. "Hemos aprovechado la diferente expresión de un tipo de proteínas, las CPEBs, en tejidos normales y tumorales", explica Raúl Méndez del IRB Barcelona.
Las CPBE son una familia de cuatro proteínas de unión a ARN (las moléculas que llevan la información de los genes para sintetizar proteínas) que controlan la expresión de cientos de genes y mantienen la funcionalidad y capacidad de reparación de los tejidos en condiciones normales. Cuando las CPEBs se desbalancean, cambian la expresión de estos genes en las células y contribuyen al desarrollo de procesos patológicos como el cáncer. "Nos hemos centrado en el doble desbalanceo de dos de estas proteínas en tejidos sanos y en tumores: por un lado tenemos CPEB4, que en estudios anteriores demostramos que tiene una expresión elevada en células cancerígenas y que es necesaria para el crecimiento del tumor, y, por el otro, CPEB1, muy expresada en tejido normal y que se pierde en el tumoral. Hemos aprovechado este desbalanceo para hacer un virus que solo ataca a las células con niveles altos de CPEB4 y bajos de CPEB1, con lo que solo afecta a las células tumorales, ignorando las sanas", señala Méndez.
"En este estudio hemos trabajado con adenovirus, una familia de virus que pueden provocar infecciones de las vías respiratorias, de las vías urinarias, conjuntivitis o gastroenteritis pero que poseen unas características que les hace muy atractivos para ser usados como terapia frente a los tumores", explica Cristina Fillat. Para ello es necesario modificar el genoma de los virus. En este estudio se insertaron secuencias que reconocen a las proteínas CPEB en regiones clave para el control de las proteínas virales. Se comprobó su actividad en modelos de in-vitro de cáncer de páncreas y se observó un control del crecimiento del tumor en modelos de ratón.
Los virus oncoselectivos que se crearon eran muy sofisticados, pues se activaban por CPEB4 pero se reprimían por CPEB1. Así, los investigadores lograron una actividad viral atenuada en células normales, mientras que en las tumorales se mantuvo o, incluso, aumentó la potencia de los virus. "Cuando los virus modificados entraban en las células tumorales, replicaban su genoma y, al salir, destruían la célula liberando más partículas del virus, capaces de infectar, a su vez, a más células cancerígenas", explica Fillat, que añade que "esta nueva aproximación es muy interesante ya que se trata de una terapia que se amplifica de forma selectiva en el propio tumor".
Dado que CPEB4 se sobreexpresa en varios tumores, esta estrategia oncoselectiva podría ser válida para otros tumores sólidos. Ahora los investigadores buscan combinar este tratamiento con terapias que ya están en la práctica clínica o en fases muy avanzadas de desarrollo, para buscar sinergias y poder ser más eficaces en el control del tumor.
Fuente: immedicohospitalario.es